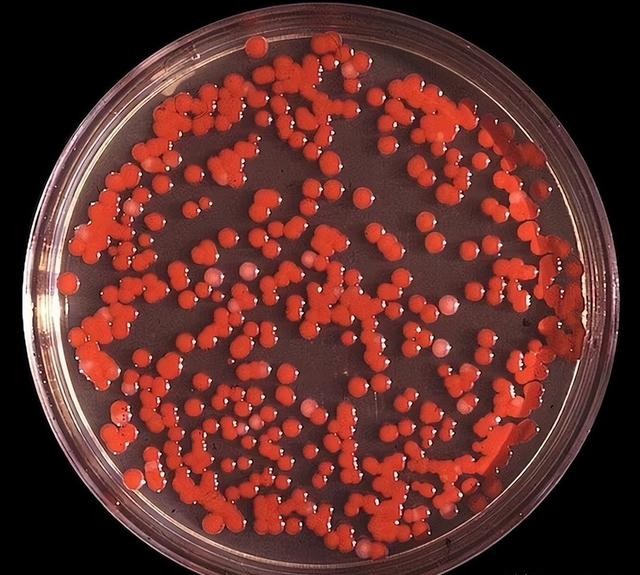

各位看官老爷,麻烦右上角点击一下“关注”,精彩内容不错过,方便随时查看。

文/编辑:大核有料

浓雾这样的天气想必大家都见过不少,不过在浓雾里待一段时间后就得流感的情况恐怕少之又少。
毕竟浓雾只是一种正常的自然情况,除非是在雾霾天气里,空气质量变差的时候,才可能对人体呼吸道造成一定伤害。

但根据凤凰卫视在本月7号的报道,大洋彼岸的美国却发生了一起不同寻常的浓雾天气。
据报道,美国在今年1月份的时候,多地出现了一种诡异的“浓雾”,这个浓雾可不简单,仔细一闻就能发现里面散发着一股奇怪的“化学”气味。

不仅如此,一位佛罗里达州居民在浓雾中待了10分钟后,回到家身上就出现了流感的症状,不停打喷嚏不说,眼睛还异常肿胀,除此以外,还伴随着发烧以及肚子抽筋的症状。
离谱的是,有这种感觉的还不止这一位居民,许多生活在美国的人也遇到了类似的情况。

很快,各种阴谋论在美国互联网上开始传播,不少人纷纷怀疑,是不是美国军方又在拿当地人进行某种不为人知的生物武器实验?
那么这场浓雾到底有何特殊之处?美国本土居民为何会产生这种怀疑呢?

不同寻常的浓雾
从佛罗里达州这位居民发布的现场照片不难发现,他的身后能见度非常低,而他本人则在这片浓雾中缓慢行走,也没有戴口罩做防护。
据该男子声称,在这些浓雾里,还有一股奇怪的化学物品的气味,闻起来就像是被烧焦的塑料。

但奇怪的是,他附近并没有焚烧垃圾的地方,所以气味从何而来,他自己也不知道。
除此以外,一位生活在蒙大拿州的网友,也在社交平台上发布了她那边的天气情况。

从现场照片中能很清楚地发现,当地正在下雪,但也能看到部分雾气,空气中同样有一股奇怪的味道。
生活在马萨诸塞州的当地居民也在社交平台上上传了当地的照片,他利用手电筒的灯光照射后发现,空气中存在大量的颗粒物。

一位来自堪萨斯州的女网友也分享了她所在的地方的天气照片,照片拍摄地在一条公路上,整体能见度不足500米,而且这种情况已经持续了大概一周的时间。

类似的情况在美国不少州都有出现,如果说只是正常的天气情况的话,那么那些诡异的怪味到底是从哪来的呢?
这没人说得清,但不少网友表示,在这样的空气环境中,他们的呼吸道也受到了一定损伤,离谱的是,有些地方存在奇怪气味的时间已经持续了数月之久。

除了美国,位于加拿大的网友也发现了这种情况,在巨大的浓雾中,存在颗粒巨大的雾霾颗粒,这些颗粒物就像雪花一样,在当地上空四处飘荡。
对此,美国气象局方面给出的解释是,这是一种正常的浓雾天气,让当地居民不必太过担心。

但显然,这种解释并不能说服生活在当地的网友。
不少网友在发文的时候表示,自己又成了可怜的化学实验小白鼠!

那么生活在美国的网友,为何会产生这种阴谋论呢?
美国人体实验黑历史
这就不得不提以往美军做过的一些黑历史了。
在1950年9月下旬的时候,生活在加州旧金山湾区的居民,同样遇到了充满奇怪味道的浓雾天气。

起初当地人对此并不怎么重视,但随着时间的推移,生活在旧金山的当地人慢慢地身体出现了许多病症,甚至有病情严重的居民,不得不选择到医院就医。
这些患者里,有尿路感染的,有感染肺炎的,而这一切都和这场浓雾有关。

因为事发的时候正值秋季,按理来说当地不会出现如此诡异的浓雾天气,但它就这样发生了。
而且根据医生检查发现,这些患者要么感染了一种名叫“粘质沙雷菌”的病原体,要不就感染了“萎缩芽孢杆菌”的病原体。
诡异的是,这两种病原体在北美地区并不常见,至于这些人的感染原因,在当时一直都是一个谜。
直到1977年的时候,美国军方在参议院的听证会上,对此事进行了辩解,原来当时美国军方正在研究一种新式生物武器,在研发成功后,便想着进行实验验证。

于是就在旧金山附近的海域进行了大量的喷洒实验,没过多久,在海洋季风的裹挟下,这些带有病菌的就席卷了旧金山,随后不少当地人的身体就出现了严重的病症情况。
这就是美军历史上臭名昭著的“海洋飞沫行动”!

实际上,这还是不美国军方在那个年代做的唯一一起生物武器实验,在首都华盛顿、纽约这样的大城市,他们同样在周边释放了大量的萎缩芽孢杆菌。
此事在被揭露出来后,美国举国哗然。

对此,美国军方一直强调,他们这样做只是为了“模拟”美国遭到生化袭击时的情况,并坚称他们当时释放的这些病菌对“人体无害”!
更恐怖的是,美国军方做这些实验全都得到了上层领导的点头,也就是说,当时那些付出生命的美国人,他们成了军方研究生化武器的实验对象!

除此以外,美国军方为了研究化学武器,同样也做过很多人体实验。
根据1986年美国众议院发布的有关放射性物质人体实验报告显示,美国研发原子弹时执行的曼哈顿计划中,就有往活着的人体里注射具有极强放射性的钴的黑历史。

而参与实验的人,对此毫不知情,而美国军方则把这些参与实验的美国公民称为“荷兰猪”!
同样在这份报告中,在上世纪六七十年代的时候,美国军方还往一些监狱囚犯的睾丸里注射放射性物质,造成这些人出现极为严重的生育缺陷,为活命不得不接受结扎手术!

除了美国军方外,CIA(美国中央情报局)也是做人体实验的一把好手!
他们当时为了研究能让人说真话的药物(俗称吐真剂),中情局的人甚至把研究所改装成了“妓院”,放出“妓女”招嫖,一旦嫖客来到实验室里,就会被诱骗至床上,然后被注射一些精神类药物进行实验!

而这些精神类药物,就是非常著名的致幻性毒品LSD,除了普通百姓外,为了做这些实验,他们甚至对自己的内部人员乃至军人下手,将他们也视为研究的实验对象。
这些事情全都是背锅官方自己公布出来的,很多都还有详细的文件资料记载。

在2022年的时候,随着俄乌战争爆发,当时俄罗斯军队就在乌克兰境内发现了多个美国建立的生物实验室,同时还有大量文件被俄方缴获!

根据美国自己公布的数据,目前全球范围内已知的,由美国建立的生物实验室,遍布30多个国家,总计336个!
至于美国有没有在这些国家内部进行生物武器实验,目前无从知晓。

即便是在被俄罗斯方面揭老底后,美国方面却始终没有透露,他们与乌克兰境内的生物实验室存在哪些联系,同时也不透露具体的实验内容。
从美国这些过往行径中,如今美国民众再次遇到了1950年的那种情况,自然也会产生怀疑,

至于这次笼罩在美国多地上空的浓雾,到底是不是美国军方的又一次生物武器实验,目前还不清楚。
结语
目前而言,美国气象局方面对此解释还是一次正常的天气变化,但他们也承认这种情况比较反常,同时向美国民众发布了做好预防的措施的通告。

至于网友们的阴谋论,其实也没有真实证据做支撑,也没有足够的证据说明这次反常天气是人为的,所以,他们现在能做的也只有自己做好防护措施,减轻对身体的伤害就行。
参考:
凤凰卫视美洲台:美国多地笼罩“神秘”雾气 多人声称接触后有流感症状 2025年01月07日
央视新闻:北美观察丨打开美国历史上的人体试验(下)阳光下的黑幕 2021-06-20
环球网:特稿:美国在乌克兰开展生物武器研究用心险恶 2022-03-22
评论列表